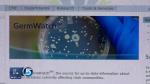

Estimated read time: 2-3 minutes
This archived news story is available only for your personal, non-commercial use. Information in the story may be outdated or superseded by additional information. Reading or replaying the story in its archived form does not constitute a republication of the story.
SALT LAKE CITY — Utah emergency rooms are receiving visits from many people complaining of the flu or flu-like symptoms, and a lot of children are out of school suffering as well. However, there is now a new method to discover if you are at risk for getting sick.
A new website tracks cases of the flu, and many other diseases. Intermountain Healthcare recently launched GermWatch which gathers information from labs, hospitals and clinics throughout the state. People can discover if there are more sick people in their area and if they are more at risk of getting sick.
Intermountain healthcare has 23 hospitals and numerous clinics throughout the state, and the "GermWatch" website updates the latest trends, and allows you to look at specific sickness rates in your area. The diseases and illnesses range from Crytosporidium to Pertussus, and people can locate what is afflicting the specific region they live in.
During the winter, the respiratory virus is the most common illness. GermWatch uses color coded maps, and red indicates the highest positive tests for the bug.
In Salt Lake County, the 84119 zip code has seen a high rate of illness in the past month. There is also a large red area in Weber County that's seeing a lot of cases; Eagle Mountain, Saratoga Springs in Utah County, and parts of St. George are seeing a lot of positive tests.
"GermWatch" is a hybrid of a program that was developed by the Utah Health Department, University Healthcare and IHC during the 2002 Winter Olympics to detect bioterrorism threats. Dr. Per Gesteland at primary Children's Medical Center later adapted it to track everyday germs.
Not only does "GermWatch" show where the germ-outbreaks are most prevalent, it also tracks how certain diseases are responding to specific treatments used by doctors. For example, if someone went to a doctor thinking that they had strep throat but GermWatch shows another type of virus is going around, then that helps the doctor prescribe the right medicine.
The website also allows you to track disease rates on a weekly, monthly, six-month and yearly rate.